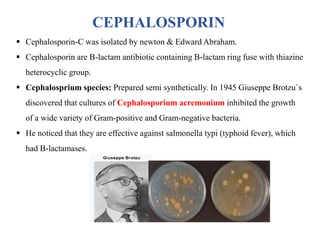
CEPHALOSPORIN
 Cephalosporin-C was isolated by newton & Edward Abraham.
 Cephalosporin are B-lactam antibiotic containing B-lactam ring fuse with thiazine
heterocyclic group.
 Cephalosprium species: Prepared semi synthetically. In 1945 Giuseppe Brotzu`s
discovered that cultures of Cephalosporium acremonium inhibited the growth
of a wide variety of Gram-positive and Gram-negative bacteria.
 He noticed that they are effective against salmonella typi (typhoid fever), which
had B-lactamases.

This document provides information about antibiotics, including their history and classifications. It begins with definitions of antibiotics and discusses their discovery, including the discovery of penicillin by Alexander Fleming in 1928. It then classifies antibiotics based on their spectrum of activity (narrow vs broad), source (natural, semisynthetic, synthetic), mechanism of action, and chemical structure. Specific examples are given for different classes. The remainder discusses various penicillins and cephalosporins, providing their structures and uses for treating bacterial infections.